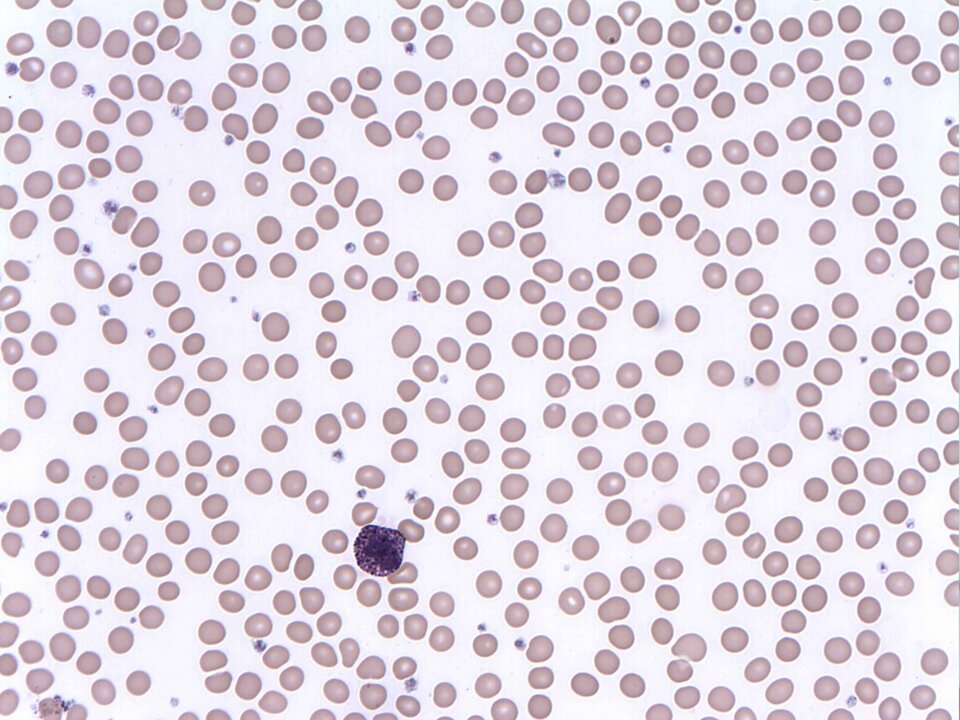
Na fotografii z mikroskopu świetlnego w powiększeniu stukrotnym znajdują się bazofile, czyli leukocyty, których cytozol wypełniony jest ziarnistościami barwiącymi się na kolor niebieski. Mają kulisty kształt i wydłużone, segmentowane jądro z dwoma lub więcej przewężeniami. Średnica bazofilów osiąga wielkość ok. 10 μm.

Przeczytaj
Krew i jej funkcje
W ciele zwierząt krążą różne płyny. Pełnią one określone funkcje, np. odżywcze, transportowe czy odpornościowe. Jednym z nich jest krew, która – krążąc w organizmie – zapewnia łączność między poszczególnymi częściami ciała. Najważniejsze funkcje krwi przedstawia poniższa ilustracja interaktywna.
Składniki krwi
Z morfologicznego punktu widzenia krew jest tkanką łączną. Jak każdy rodzaj tkanki tego rodzaju krew składa się z komórek zawieszonych w płynnej substancji międzykomórkowej (macierzy). Ową płynną częścią krwi jest osocze. Stanowi ono ok. 55% objętości krwi, zaś komórki (i ich fragmenty), określane mianem elementów morfotycznych krwi, odpowiednio ok. 45%.
Wśród komórek wyróżnia się krwinki czerwone (erytrocyty) i krwinki białe ().
Krwinki czerwone są bardzo liczne – stanowią ok. 99,7% wszystkich elementów morfotycznych krwi. Ich podstawową funkcją jest transport tlenu i dwutlenku węgla.
Krwinki białe to komórki wyspecjalizowane w obronie organizmu przed szkodliwymi drobnoustrojami. Mogą przemieszczać się ruchem pełzakowatym w naczyniach krwionośnych, a nawet przedostawać przez ich ściany do tkanek. Niektóre z nich są fagocytami, które pochłaniają i trawią drobnoustroje oraz szczątki obumarłych komórek. stanowią zaledwie ok. 0,1% elementów morfotycznych krwi, ale są ich najbardziej zróżnicowaną grupą. Różnią się między sobą wielkością, kształtem jądra komórkowego oraz obecnością rozmaitych ziarnistości w cytoplazmie. We krwi człowieka występują niezawierające ziarnistości – agranulocytyagranulocyty (monocyty i limfocyty) oraz zawierające ziarnistości, czyli granulocytygranulocyty (neutrofile, bazofile i eozynofile). Granulocyty mają charakterystyczne, płatowate jądra komórkowe.
Krew zawiera również fragmenty komórek – płytki krwi (trombocyty), które biorą udział w procesie krzepnięcia krwi. Stanowią one 0,2% elementów morfotycznych krwi.
Klasyfikacja i prawidłowe wartości liczbowe elementów morfotycznych krwi człowieka
Elementy morfotyczne | Liczba w mul (mmIndeks górny 33) | |
Erytrocyty | 4,5–5,5 mln | |
|---|---|---|
% leukcytów | 5–8 tys. | |
Granulocyty | ||
Neutrofile (granulocyty obojętnochłonne) | 55–65 | |
Eozynofile (granulocyty kwasochłonne) | 2–4 | |
Bazofile (granulocyty zasadochłonne) | 0,5–1 | |
Agranulocyty | ||
Limfocyty | 25–35 | |
Monocyty | 4–8 | |
Trombocyty | 200–300 tys. | |
Indeks górny Na podstawie: Encyklopedia biologiczna, pod red. Zdzisława Otłęgi, Wydawnictwo OPRES, Kraków 1998. Indeks górny koniecNa podstawie: Encyklopedia biologiczna, pod red. Zdzisława Otłęgi, Wydawnictwo OPRES, Kraków 1998.
Elementy morfotyczne | Liczba w mul (mmIndeks górny 33) | |
|---|---|---|
Erytrocyty | 4,5–5,5 mln | |
5–8 tys. | ||
Trombocyty | 200–300 tys. | |
Elementy morfotyczne | % | |
|---|---|---|
Granulocyty | ||
Neutrofile (granulocyty obojętnochłonne) | 55–65% | |
Eozynofile (granulocyty kwasochłonne) | 2–4% | |
Bazofile (granulocyty zasadochłonne) | 0,5–1% | |
Agranulocyty | ||
Limfocyty | 25–35% | |
Monocyty | 4–8% | |
Indeks dolny Na podstawie: Encyklopedia biologiczna, pod red. Zdzisława Otłęgi, Wydawnictwo OPRES, Kraków 1998. Indeks dolny koniecNa podstawie: Encyklopedia biologiczna, pod red. Zdzisława Otłęgi, Wydawnictwo OPRES, Kraków 1998.
Mikroskopowe zdjęcia elementów morfotycznych krwi
Erytrocyty żaby żyją nawet dwa lata, podczas gdy u człowieka okres ten wynosi ok. 120 dni. Obumarłe erytrocyty są rozkładane w śledzionie, a na ich miejsce w szpiku czerwonym powstają nowe komórki. Erytrocyty wszystkich kręgowców, z wyjątkiem ssaków są stosunkowo duże, owalne i zawierają jądra komórkowe. Krwinki czerwone ssaków są niewielkie i pozbawione jądra oraz innych organelli (mitochondriów i aparatu Golgiego).

Limfa
Kręgowce mają dwa rodzaje płynnej tkanki łącznej: krew i limfę. Limfa, nazywana także chłonką, tworzy się na skutek przenikania płynu tkankowego z przestrzeni międzykomórkowych do naczyń limfatycznych. Główną rolą limfy jest udział w reakcjach odpornościowych oraz transport substancji odżywczych.

Hemolimfa
W ciałach niektórych bezkręgowców krążą płyny o podobnych funkcjach, ale nieco innym składzie niż krew i limfa kręgowców. Takim płynem jest hemolimfa. W składzie hemolimfy nie ma krwinek czerwonych, a barwniki przenoszące tlen i dwutlenek węgla rozpuszczone są w osoczu, np. hemoglobinahemoglobina (czerwony barwnik) u skąposzczetów, chlorokruoryna (barwnik o zielonej barwie) u wieloszczetów lub hemocyjanina (niebieska lub bezbarwna) u mięczaków. Hemolimfa owadów nie zawiera barwników oddechowych i nie transportuje gazów oddechowych. Tę funkcję pełnią tchawki, a hemolimfa przenosi jedynie substancje odżywcze. Charakterystycznymi składnikami tego płynu są również zdolne do fagocytozyfagocytozy komórki pełzakowate, które pełnią ważną rolę w odporności zwierząt.

Słownik
(gr. a – nie; łac. granulum – ziarnko; gr. kýtos – komórka) grupa , które nie zawierają ziarnistości w cytoplazmie
antygen wywołujący reakcję alergiczną
substancje wywołujące reakcję odpornościową organizmu
(gr. phágos – pożeracz, kýtos – naczynie, komórka) typ endocytozy polegający na wchłanianiu przez niektóre komórki cząsteczek pokarmu, mikroorganizmów, ciał obcych
(łac. granulum – ziarnko; gr. kýtos – komórka) rodzaj , które zawierają liczne ziarnistości i podzielone na segmenty jądro komórkowe
czerwony, zawierający żelazo barwnik białkowy rozpuszczony w osoczu krwi (np. u pijawek) lub znajdujący się w erytrocytach (u kręgowców), zdolny do przenoszenia tlenu i dwutlenku węgla w organizmie dzięki nietrwałemu łączeniu się z tymi substancjami
rodzaj białek wydzielanych przez limfocyty w przebiegu reakcji odpornościowej. Immunoglobuliny charakteryzują się zdolnością do swoistego rozpoznawania antygenów
osocze krwi pozbawione fibrynogenu (białka biorącego udział w procesie krzepnięcia krwi)